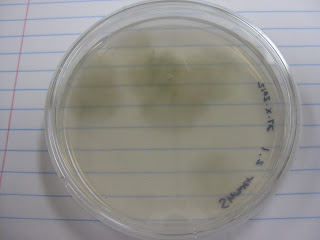

On this day, I observed many of my cultures and tried to identify some using Barnett and Hunter (2010). First I observed my culture from the wasp nest, which had several different colonies growing (Fig. 1).
 |
| Fig. 1 Wasp nest plate |
 |
| Fig. 2 Colonies isolated from moldy cricket |
I then observed my plates isolated from the shower mold (Figs. 3-5). Fig 3 is the original plate, while Figs. 4 and 5 were isolated on water agar from the first plate. One plate was inoculated via standard sterile technique with a probe (Fig. 4), while the other was inoculated by sterilely cutting a chunk of agar from the original plate and placing it in the middle of the new water agar plate (Fig. 5). Both plates exhibit very sparse growth.
 |
| Fig. 3 Original shower mold plate |
|
| Fig. 4 Fungi isolated from original shower mold plate using standard inoculation technique |
 |
| Fig. 5 Very sparse fungal growth on plate isolated from original shower mold plate via transfer of agar block |
 |
| Fig. 6 Mass of hyphae at 10x magnification (tape mount). |
 |
| Fig. 7 One lone conidiophore |
 |
| Fig. 8 Possibly Aspergillus sp. |
 |
| Fig. 9 Possibly Aspergillus sp. |
Conclusions
Looks like I am still getting a lot of very common fungi. Maybe some of my other cultures will prove to be interesting.
All for now,
C
No comments:
Post a Comment